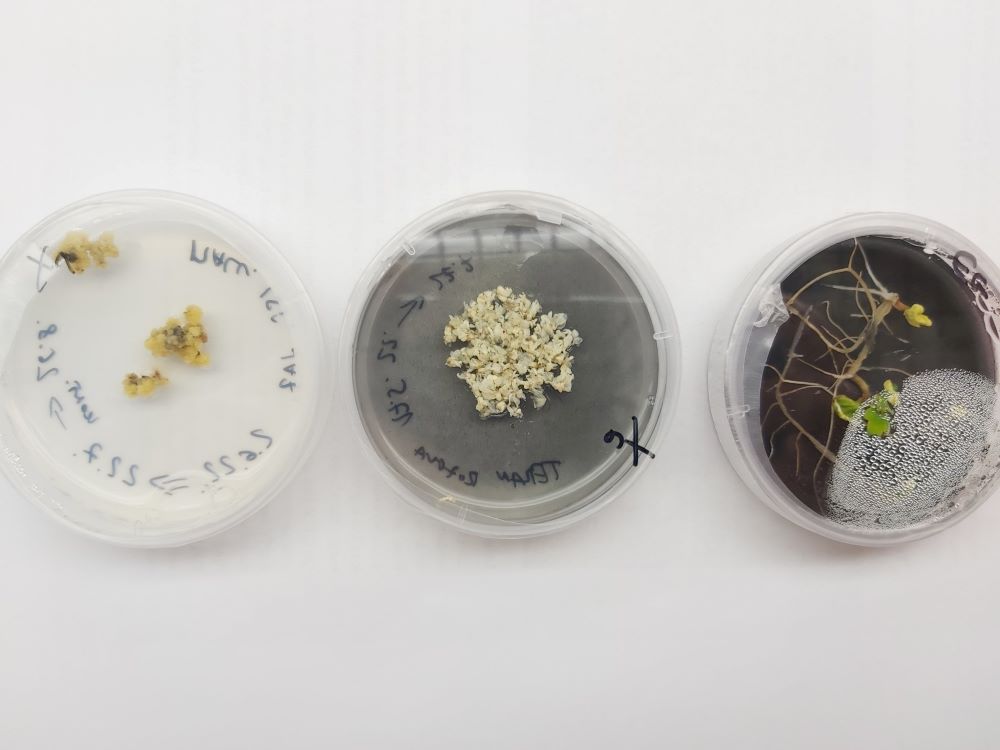

Oni su doktori za vinograde - trenutno rade na ozdravljivanju plavca malog i grka za vinare s Hvara i Korčule. Ideja je uzgajivačima ponuditi mogućnost ozdravljivanja njihovog klona neke sorte po izboru.
Patent Prirodoslovno-matematičkog fakulteta Sveučilišta u Zagrebu mogao bi biti spas za vinogradare koji muku muče s virusima koji smanjuju prinose i vijek vinove loze i cijelih vinograda. A o čemu je konkretno riječ razgovaramo s dvoje istraživača s PMF-a, redovitom profesoricom, dr. sc. Dunjom Leljak - Levanić i izvanrednim profesorom, dr. sc. Nenadom Malenicom koji su svoje znanje spremni podijeliti s vinogradarima i tako im pomoći u ozdravljivanju vinove loze od virusa protiv kojih se ne može boriti kemijskim sredstvima.
Dunja Leljak Levanić rješenje koji su ovo dvoje znanstvenika otkrili i zaštitili objašnjava ovim riječima - kultivirana vinova loza višegodišnja je drvenasta i (uglavnom) samooplodna biljna vrsta. S obzirom na to da se spolnim razmnožavanjem geni roditelja nanovo kombiniraju, potomak spolnog razmnožavanja vinove loze gubi svoj sortni identitet (jedinstvenu kombinaciju gena). Poznate tradicionalne sorte potječu od nekog davnog oprašivanja i spolnog razmnožavanja i izvorno su dobivene iz sjemena: vinogradari bi zapazili nove poželjne osobine pojedinog trsa proizašle iz kombinacije roditeljskih genoma i počeli upravo njega vegetativno razmnožavati kako bi svojstvo ostalo sačuvano. Tako su nastajale današnje sorte, a radi trajnog očuvanja sortnog identiteta (poželjnog genotipa) u praksi se sorte vinove loze razmnožavaju isključivo vegetativno: reznicama i nacjepljivanjem/navrtanjem.

Shema ozdravljivanja
S druge strane, za neke suvremene sorte zaslužni su oplemenjivači koji su ciljano križali dvije odabrane sorte i probrali najbolje loze (trsove) među potomstvom. Nažalost, vegetativno razmnožavanje je, osim dobrih osobina, trajno fiksiralo i neke nedostatke, a to su prije svega osjetljivost na bolesti i nametnike. Neki od tih problema mogli bi se riješiti križanjem s drugim otpornim vrstama loze, ali takve hibride potrošači ne žele pa ih stoga ni vinogradari ne sade masovno. Gljivične bolesti i nametnici zato se suzbijaju kemijskim preparatima. Međutim, za jednu kategoriju bolesti nema ni kemijskog rješenja, a to su virusi.
Virusi smanjuju vitalnost i značajno skraćuju životni vijek vinograda
Vinova loza je domaćin za oko 80 različitih vrsta virusa, od kojih neki dugoročno predstavljaju ozbiljan ekonomski problem. Naime, virusi vinove loze ne ubijaju biljku odmah, nego joj malo po malo smanjuju vitalnost i značajno skraćuju životni vijek vinograda.
Nadalje, virusima zaraženi vinogradi imaju manji prinos, manju kvalitetu mošta (rastu kiseline, padaju šećeri), veću osjetljivost na gljivične bolesti, veću osjetljivost na nisku ili visoku temperaturu, teže zakorjenjivanje sadnog materijala te slabije srastanje podloge i plemke. Ukratko, kvaliteta vina dobivena iz virusima zaraženih vinograda ne doseže kvalitetom a ni kvantitetom razine koje su potencijal sorte ili kraće rečeno visoka kvaliteta hrvatskih vina nije ona maksimalna koja bi se mogla postići.
Virusne zaraze nije moguće riješiti kemijskim sredstvima, nego je zaražene biljke potrebno ukloniti iz vinograda i zamijeniti ih zdravima, odnosno sadni materijal za podizanje novih vinograda mora biti oslobođen od virusa.Standardna tehnika dobivanja zdravog sadnog materijala temelji se na kulturi vršnog meristema u kombinaciji s krioterapijom. Ukupna učinkovitost ove metode je do 25% pri čemu neke klase virusa nije moguće potpuno eliminirati.
Slijedom tih saznanja na našoj matičnoj institiciji, Prirodoslovno-matematičkom fakultetu u Zagrebu, razvijen je patentirani laboratorijski postupak ozdravljivanja zaražene vinove loze koji aseptičkim vegetativnim umnožavanjem dovodi do eliminacije virusnih i drugih patogena (npr. fitoplazmi) uz očuvanje sortnog identiteta početne biljke. Postupak je do sada testiran na desetak autohtonih hrvatskih sorti. Ovom metodom, u relativno kratkom vremenu, iz inficiranog biljnog materijala moguće je dobiti velik broj jedinki potpuno oslobođenih od virusa. Istraživači s PMF-a uspješnost uklanjanja virusa iz početnog materijala doveli su do razine 90 – 100%.
Zdrava loza u tri faze
O problemu i načinu rješavanja više nam je rekao izv. profesor dr. sc. Malenica, koji kaže:
Od 2013. do 2019. godine u Republici Hrvatskoj proizvedeno je oko 11.300.000 komada cjepova vinove loze. Međutim, prema izvješću Hrvatskog centra za poljoprivredu, hranu i selo iz 2018., samo oko 54 % spada u kategoriju tzv. certificiranog sadnog materijala, tj. onog koji potječe iz baznih (osnovnih) matičnih nasada, dokazano slobodnih od virusa i ostalih patogena. Postojeći bezvirusni sadni materijal u Hrvatskoj dobiven je selekcijom zdravih jedinki iz vinograda ili ozdravljivanjem u inozemnim laboratorijima.
Poznato je da virusima zaražene sadnice vinove loze imaju lošije parametre rasta, niži prinos, kraći životni vijek te lošiju kakvoću vina. Primjerice, produktivni život vinograda zaraženog virusom GFLV je 15 – 20 godina kraći, a grožđe, mošt i vino imaju niži sadržaj šećera i povećanu ukupnu kiselost, što dovodi do znatnih ekonomskih gubitaka.
Ministarstvo poljoprivrede nedavno je usvojilo izmjene i dopune Pravilnika o stavljanju na tržište materijala za vegetativno umnažanje loze (NN49/2020), kojim se usvajaju standardi Europske unije u pogledu kvalitete sadnog materijala koji se smije stavljati na tržište. Prema propozicijama Europske organizacije za zažtitu bilja (EPPO-a), za bezvirusni certifikat vinova loza ne smije biti zaražena s niti jednim od ovih pet virusa: ArMV, GFLV, GLRaV- 1, GLRaV-3 i GFkV.
Vitis in vitro
Ideja je uzgajivačima ponuditi mogućnost ozdravljivanja njihovog klona neke sorte po izboru
O načinu ozdravljenja, prvim rezultatima i kome je ono potrebno dvoje znanstvenika nadalje kažu:
Ideja je uzgajivačima ponuditi mogućnost ozdravljivanja njihovog kl ona neke sorte po izboru(https://zdravaloza.biol.pmf.hr/) bez slanja u inozemstvo. Vinogradar nam pošalje uzorak vinove loze koji je odabrao u optimalno vrijeme za našu proceduru, a mi mu isporučujemo dogovoreni broj biljaka u pravilu u roku od godinu dana. Uz biljke vinogradar će dobiti i potvrdu o sanitarnom statusu biljke tj. dokaz da je materijal oslobođen od virusa.
Specifičnost naše usluge ozdravljivanja jest da se ona obavlja u Hrvatskoj, da time stvaramo lokani know-how, smanjujemo troškove za uzgajivača i doprinosimo očuvanju hrvatskih autohtonih sorti. Svaka ozbiljna vinska država ima vlatite kapacitete za ozdravljivanje i plasman na tržište isključivo zdravih sadnica vinove loze.
Trenutno radimo na ozdravljivanju plavca malog i grka za vinare s Hvara i Korčule.